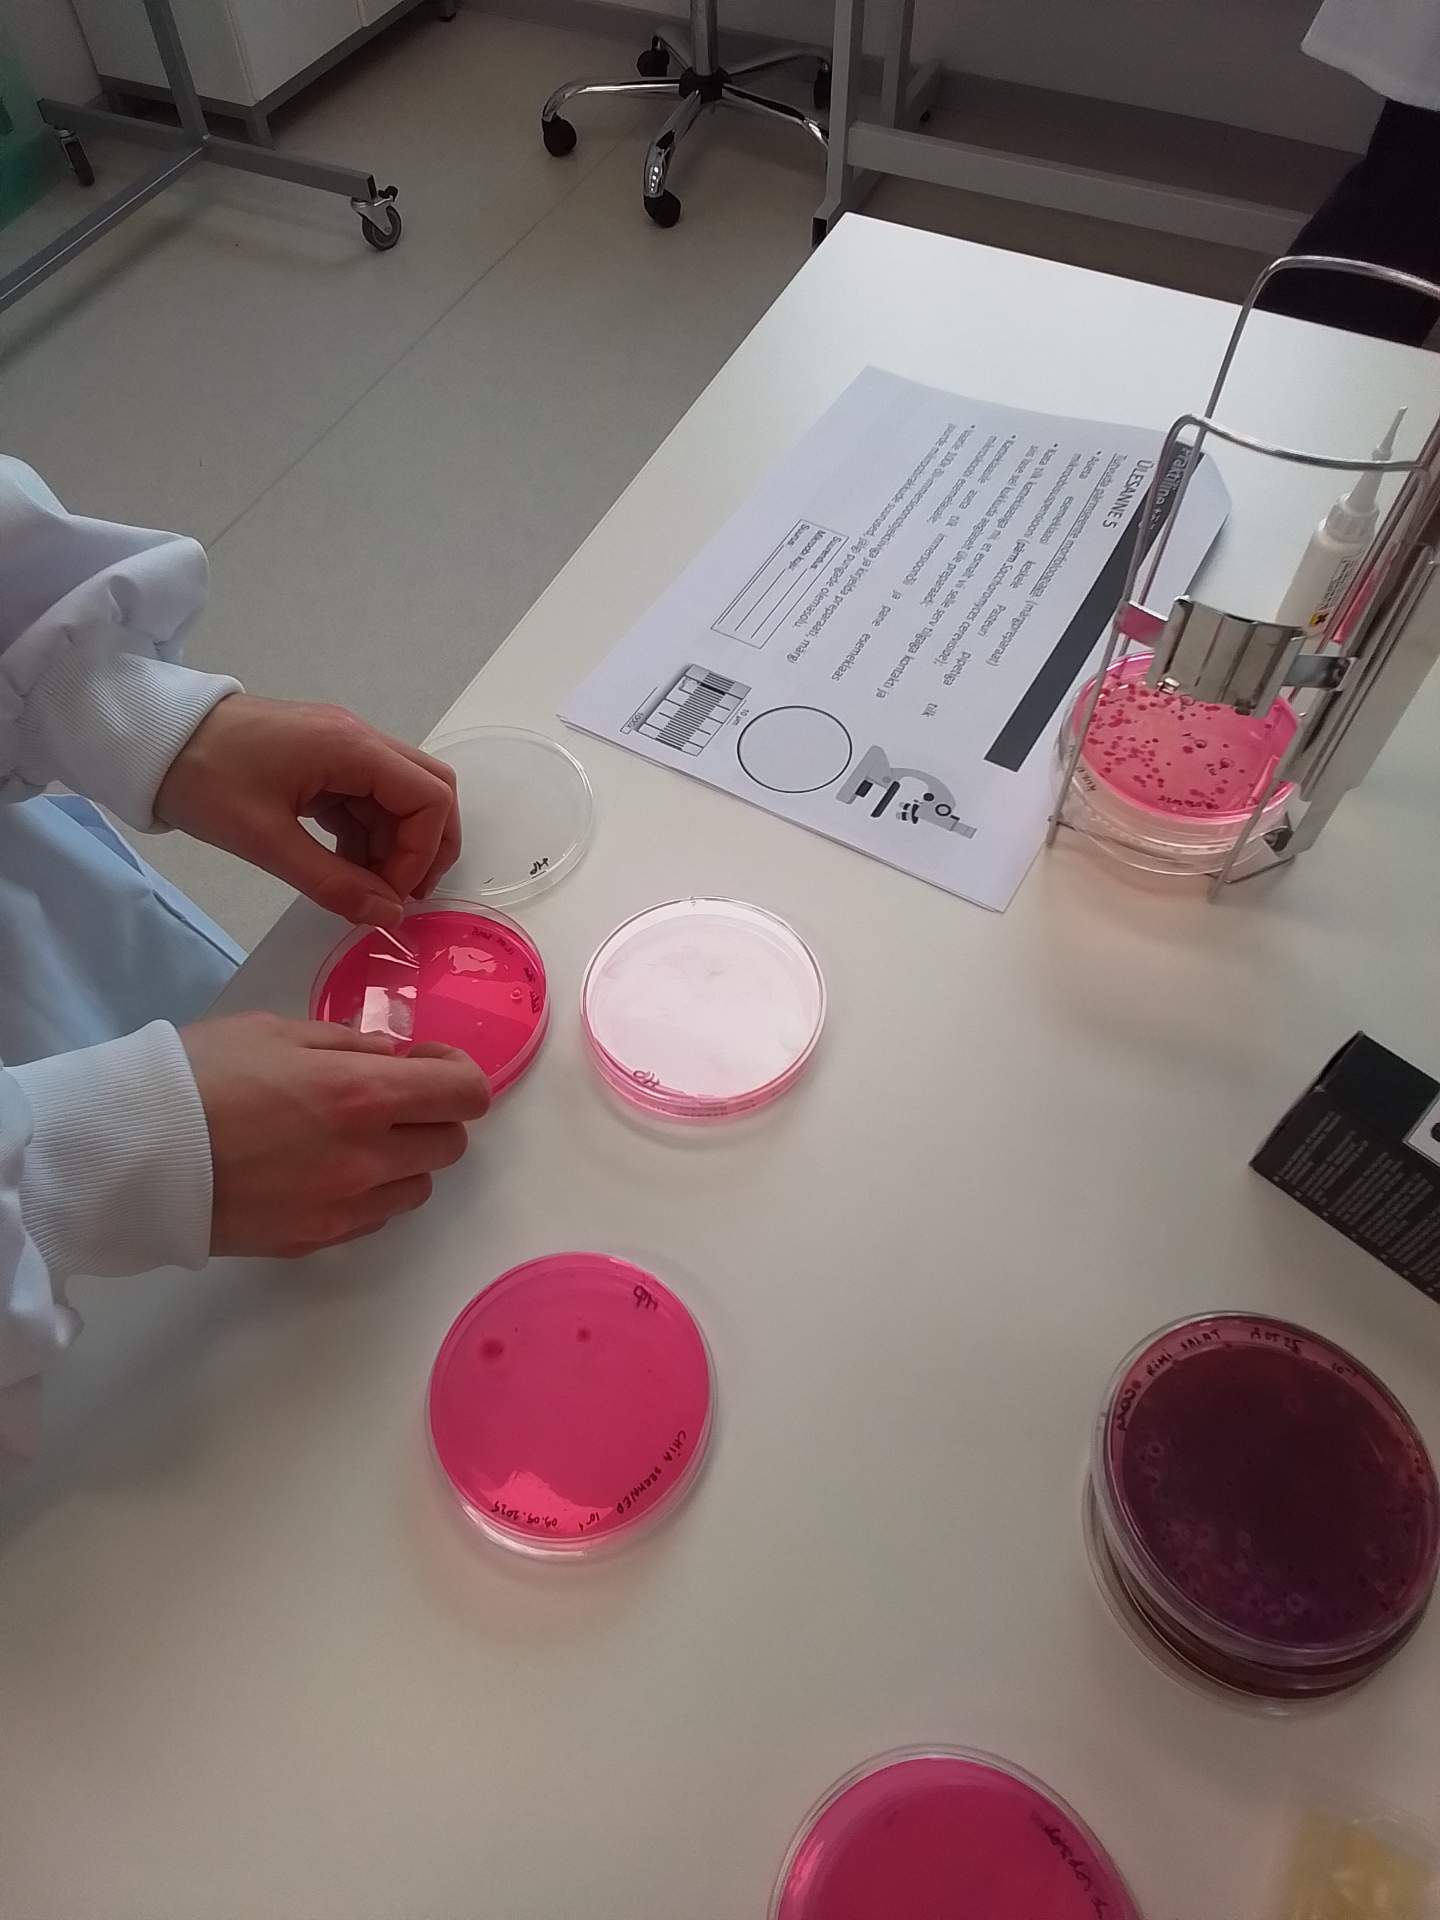

15. mail 2025 osalesid loodusteadustega seotud moodulites õppivad 18 gümnasisti Mikrobioloogia töötoas. Õpilasi juhendasid Eesti Maaülikooli Veterinaarmeditsiini- ja loomakasvatuse instituudi, Toiduteaduse ja toidutehnoloogia õppetooli õppejõud nooremprofessor õppetooli hoidja Helena Andreson, PhD ja nooremteadur Liis Lutter, MSc.
Noored said jäädvustada oma kätel (enne ja pärast nende pesemist) elutsevaid potentsiaalselt haigusttekitavaid mikroobe streriilsel veriagarasöötmel. Proove inkubeeritakse Tartus ja hiljem antakse meile teada tulemustest. Tutvustati söötmega täidetud Petri tasside markeerimist.
Seejärel näidati õpilastele põnevat õhuanalüsaatorit Biotest Hycon Air Sampler, millega on võimalik määrata mikroobide arvu õhus. Laboriruumis lasti läbi seadme 500 liitrit õhku.
Järgmise ülesandena oli vaja määrata mikroobide arvu pindadelt. Selleks tehti tampoonkülv huvipakkuvalt pinnalt ja sellele järgnes test ATP luminomeetriga. Selgus, et kõige saastatumad on meie mobiiltelefonide pinnad, jalanõude tallad ja põrand. Meie noored said lisaks harjutada õli-immersioonobjektiiviga mikroskopeerimist, kus oli tarvis fokusseerida mikroskoop ja joonistada preparaatidel nähtut. Mikroskoobi abil tutvusid noored ka bakterite ja hallituste morfoloogiaga. Abivahendina kasutati kristallteipi ja esemeklaasi.
Osalejate tagasiside:
“Juhendajad olid meeldivad ja professionaalsed. Seletasid vajaliku teooria ning saime asuda proove võtma ja mikroskoobiga erinevaid preparaate vaatama. Töötoa muutis hästi huvitavaks see, et saime teha tööd vahendite ja tehnikaga, millega koolilaborites kokku ei puutu.”
“Praktikas tehes läksid asjad huvitavamaks ning aeg hakkas lendama. Väga huvitav kogemus oli kasutada mikroskoope ning näha erinevaid baktereid lähedalt. Minu jaoks jäi kõrvataha üpris palju uut: vahend luminomeeter ja mõõteühik RLU, õhuproovi vahend mikroobide arvu määramiseks õhus ja ATP.”
Täname Maaülikooli juhendajaid ja aktiivseid teadushuvilisi noori!